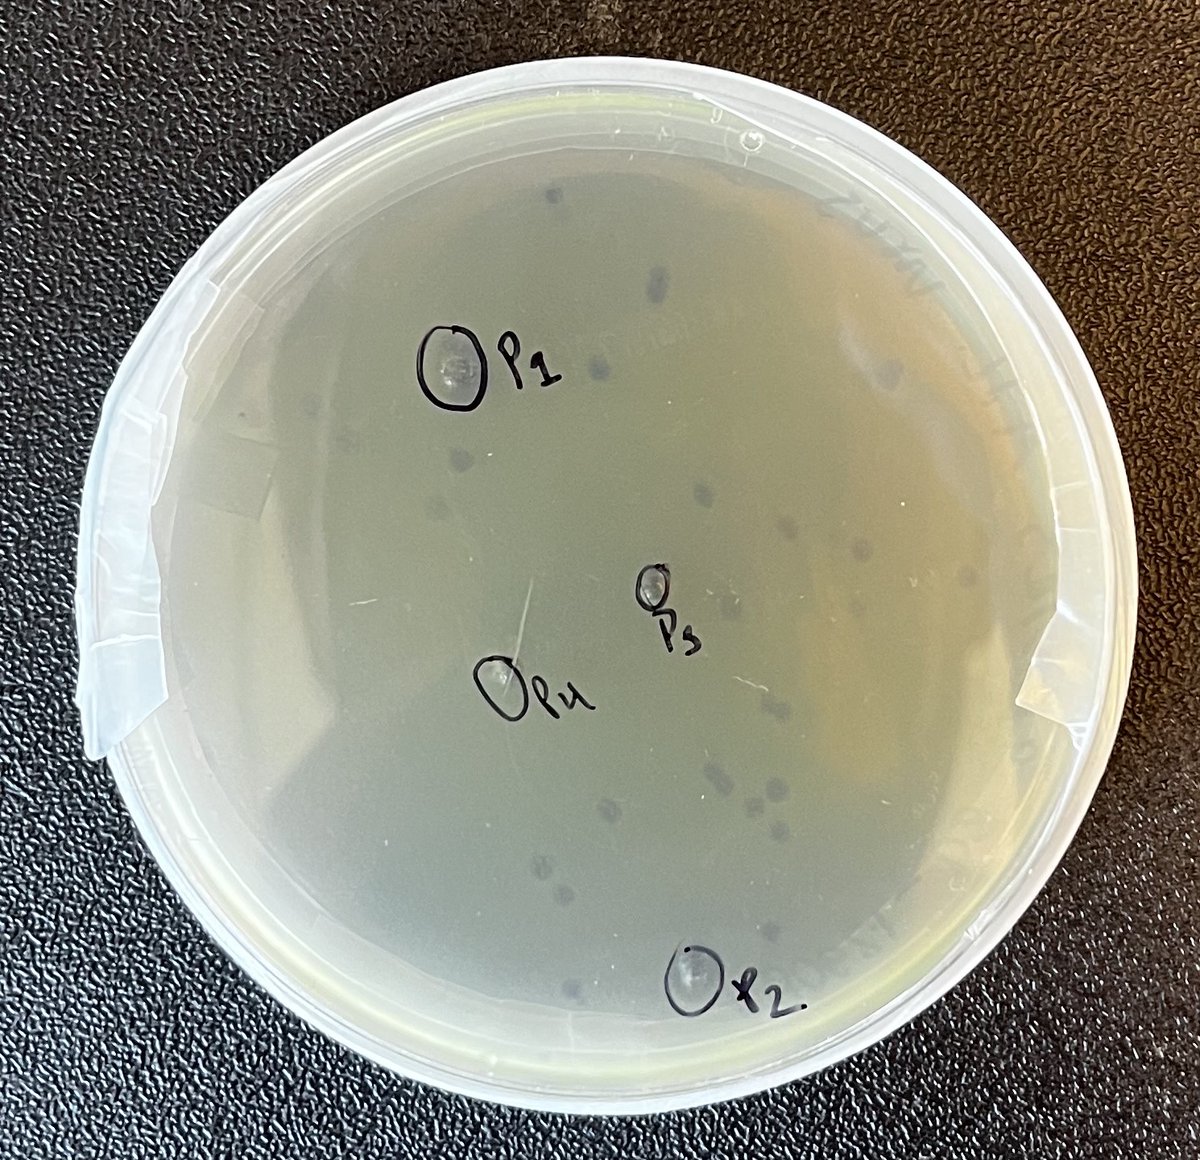
Nathan Ahlgren (@ahlgren_lab) on Twitter photo Excited to show off the lab's first cyanophage plaques from Angell and (Duklida, not pictured), two UG researchers. This is on their first go of it!
We have been relying on Marcie Marston for phage isolation in our collaboration, but it was high time to do it our selves. Excited to show off the lab's first cyanophage plaques from Angell and (Duklida, not pictured), two UG researchers. This is on their first go of it!
We have been relying on Marcie Marston for phage isolation in our collaboration, but it was high time to do it our selves.

Nathan Ahlgren
@ahlgren_lab
Microbial ecologist: phage, cyanobacteria // Assoc. prof. @ClarkUniversity // @UWOcean grad // he/him //
ID: 860561697194594306
https://nahlgren.wordpress.com/ 05-05-2017 18:27:51
1,1K Tweet
922 Followers
645 Following




Aren’t school committees meeting’s supposed to be streamed live via fb? Can’t find it there. Am I missing something? This needs to be clearly accessible/visible Worcester Public Schools Tracy O'Connell Novick Sue Coghlin Mailman - Worcester School Committee

Trust Jacob West-Roberts and The Banfield Lab to come up with nature's weirdest. 1/2 The world’s largest proteins? These mega-molecules turn bacteria into predators nature.com/articles/d4158…

Boston, population 675k, has 18 city-run pools. Worcester, population 206k, has...one. (via MASSterList)


#OSM24 conference highlight: Catching up with my former MA student Katie Crowley, seeing her poster & thriving in PhD program at UConn Marine Sciences Clark University ClarkU Biology



Looking for postdoc in #marine #microbiology #virology? We have many avenues for phage-host research: single-cell methods, 100s of #cyano & #phage isolates, bioinf analysis of monthly & weekly time-series. Happy to sponsor application for Simons Postdoc simonsfoundation.org/grant/simons-p…

Such an honor to present Prof. Akiko Iwasaki as an honorary PhD recipient at Clark University commencement today. So impressed by her work on so many fronts. Immunology. Long COVID. Vaccine development. Representation in STEM.





1/6 Excited to share our latest work University of Waterloo published in Virus Evolution on horizontal gene transfer of a #virus gene (nblA) involved in the disassembly of phycobilisomes, cyanobacterial light-harvesting complexes: doi.org/10.1093/ve/vea…



Thrilled to share that Brent Robicheau, postdoc in my lab, will be heading off to bigger and better things as a new tenure track professor! Congrats! 🎉

Had a blast sharing the wonders of #cyanobacteria #phage & #MicrobialCentrism on #MattersMicrobial podcast Also chatted about things like 3D printing, iron, photosynthesis, life in weird places, band names... so much! Thanks again Mark O. Martin #MicrobeTV Clark University